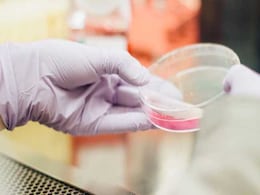

World Science Day 2021
-
{
- All
- News
- Videos
-

World Science Day For Peace And Development 2021: Know The Date, Theme, And Significance
- Wednesday November 10, 2021
- World News | Edited by NDTV Newsdesk
Science has made stellar advancements in the last century. To honour the role of science in our lives, UNESCO celebrates World Science Day for Peace and Development every year to ensure people are kept up-to-date about scientific developments.
-
 www.ndtv.com
www.ndtv.com
-

World Photography Day: An Art Form That Also Keeps Our Memories
- Thursday August 19, 2021
- C Sukumaran
On this World Photography Day, let's talk deep about photography. Photography is as much an art as it is science. The science that goes behind the lens to capture the perfect shot as much as the aesthetics that make those shots remain etched for time immemorial. Visual thinking, as we know it, is the normal way of thinking for many – we might for...
-
 www.gadgets360.com
www.gadgets360.com
-

World Science Day For Peace And Development 2021: Know The Date, Theme, And Significance
- Wednesday November 10, 2021
- World News | Edited by NDTV Newsdesk
Science has made stellar advancements in the last century. To honour the role of science in our lives, UNESCO celebrates World Science Day for Peace and Development every year to ensure people are kept up-to-date about scientific developments.
-
 www.ndtv.com
www.ndtv.com
-

World Photography Day: An Art Form That Also Keeps Our Memories
- Thursday August 19, 2021
- C Sukumaran
On this World Photography Day, let's talk deep about photography. Photography is as much an art as it is science. The science that goes behind the lens to capture the perfect shot as much as the aesthetics that make those shots remain etched for time immemorial. Visual thinking, as we know it, is the normal way of thinking for many – we might for...
-
 www.gadgets360.com
www.gadgets360.com